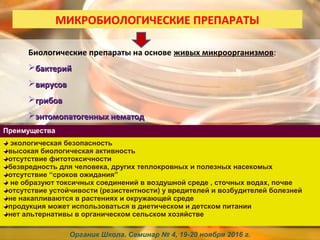

Наком Совместимость

👉🏻👉🏻👉🏻 ВСЯ ИНФОРМАЦИЯ ДОСТУПНА ЗДЕСЬ, ЖМИТЕ 👈🏻👈🏻👈🏻
Проверь совместимость медицинских препаратов, узнай, можно . . .
Наком — инструкция по применению, описание, вопросы по . . .
Наком и Фенибут - совместимость препаратов, можно ли . . .
Мирапекс и Наком - совместимость препаратов, можно ли . . .
Фенигидин и Наком: можно ли принимать вместе . . .
Бромокриптин и Наком - совместимость, можно ли пить совместно
Мексидол - проверка совместимости с другими лекарствами
Телзап - проверка совместимости с другими лекарствами
Конкор - проверка совместимости с другими лекарствами
Лизиноприл - проверка совместимости с другими лекарствами
Альфа Липоевая Кислота При Рассеянном Склерозе
Спрей Для Носа Назонекс Цена Отзывы
Макситрол Аналоги
Совместимость НАКОМ ® с ФЕНАЗЕПАМ При одновременно применении леводопы с ингибиторами МАО (за исключением ингибиторов МАО типа B) возможны нарушения кровообращения (прием ингибиторов МАО следует прекратить за 2 недели до начала приема леводопы) .
Мадопар и Наком это весьма схожие по действию препараты, но точными аналогами они не являются, состав действующих веществ у них все же отличается . Любой из этих препаратов, как отдельно, так и совместно с Циклодолом, можно применять только строго по личному назначению лечащего врача .
⭐⭐⭐⭐⭐ Наком и Фенибут - совместимость препаратов: можно ли применять одновременно, сочетание, взаимодействие, совместное применение препаратов, возможные побочные эффекты .
⭐⭐⭐⭐⭐ Мирапекс и Наком - совместимость препаратов: можно ли применять одновременно, сочетание, взаимодействие, совместное применение препаратов, возможные побочные эффекты .
Можно ли принимать вместе Фенигидин и Наком - совместимость препаратов Наком действующие вещества (МНН): Карбидопа, Леводопа
Бромокриптин и Наком Проверка совместимости препаратов Бромокриптин и Наком . Можно ли пить указанные лекарства совместно и совмещать их прием .
Взаимодействует с лекарствами: Адаптол . Алзолам . Алпразолам . Альгерика . Амиксид . Атаракс . Афобазол . Бензонал .
Проверить совместимость лекарства Телзап с другими препаратами .
Проверить совместимость лекарства Конкор с другими препаратами . 2018-2021 Combomed .ru (Комбомед) Все сочетания, сравнения и иная информация, представленные на сайте, являются справочной информацией, формируемой в . . .
Проверить совместимость лекарства Лизиноприл с другими препаратами . Проверка совместимости препарата Лизиноприл с выберите лекарство для сравнения
Фаринорм Гексэтидин
Велаксин Отзывы Врачей Психиатров
Филахромин Цена 120 Капсул
Аллергия После Парацетамола
Кампто
Местамидин Спрей Для Носа Взрослым Отзывы
Гриппферон Беременным 1 Триместр
Гербион Отхаркивающий Для Детей Отзывы
Таблетки Тамоксифен Цена В Аптеках Москвы
Дакарбазин Аналоги
Омепразол Употребление
Нитроглицерин 6
Резокластин 5 Мг Отзывы
Пиразидол Отзывы Пациентов Принимавших
Предуктал Од 80 Аналоги Цены
Что Лечит Омепразол В Капсулах
Прививка Превенар Поднимается Ли Температура
Кармолис От Чего Помогает
Гексикон Годность
Рибоксин Фармакологическое Действие
Фраксипарин 0.3 Форум
Габапентин Какая Группа
Капилар Для Ног Отзывы
Депакин Хроно И Энтерик Отличия
Сколько Давать Изопринозин Ребенку
Разовая Доза Дексаметазона Внутримышечно
Пертуссин Инструкция По Применению Взрослым Цена
Веторон Капли Цена Тольятти
Мовипреп Вкус Отзывы
Тирамин Кто Пил Отзывы
Эмоксипин Ампулы Инструкция По Применению Цена Отзывы
Сколько Стоит Лоцерил Цена
Визанна При Кисте Яичника Отзывы
Кориандр Куда
Эрлеада Мнн
Ксимедон Уфа
Зарсио 300 Мкг Цена
Триазавирин От Коронавируса Отзовик Отзывы Врачей
Сколько Стоит Троксерутин Мазь Цена
Виксипин Глазные Цена Отзывы
Теветен И Теветен Плюс В Чем Разница
Лориста 50 Действие
Фраксипарин Международное Название
Н Ка Элеутерококка Инструкция
Вермакар Вермокс
Урцевел Цена Капсулы Инструкция По Применению
Трентал 100мг Инструкция По Применению
Мидокалм Цена Пермь
Флуомизин Таблетки При Беременности 2 Триместр Отзывы
Клималанин Таблетки Цена
Димексид Для Чего Нужен Цена
Фосфалюгель Цена В Спб Аптека Озерки
Снуп Показания К Применению
Венолайф Таблетки 1000
Глюкофаж Лонг 500 Производитель
Тербинафин Канон Аналоги
Цитросепт Оригинал
Нагипол Отзывы Для Волос
Таблетки От Молочницы Флуконазол Или Флюкостат
Праджисан Прием
Фозикард Инструкция
Гевискон СПб
Троксерутин Гель Цена В Москве В Аптеках
Коронал В СПб
Кортексин Применение Отзывы
Кипферон И Ингавирин Вместе Можно
Чем Отличается Л Тироксин От Эутирокса Отзывы
Найз Цены В Аптеках Челябинска
Тиапридал Таб
Местамидин Цена Екатеринбург
Хумулин М3
Энтерол Астана
Сколько Стоит Препарат Назонекс
Гроприносин И Валацикловир Что Лучше
Рокона Таблетки Цена Отзывы
Флотидин
Легалон Форум Врачей
Неванак Цена
Нобазит Цена В Краснодаре Социальная Аптека
Бисопролол 5 Г 800
В Каких Продуктах Содержится Триптофан Список
Кипферон Свечи Для Детей Отзывы Врачей
Лахезис Плюс При Климаксе Отзывы Цена
Диован Мнн
Сколько Стоит Радевит Мазь Цена
Biloba Гинкго Билоба
Солкосерил Трещина Отзывы
Нитроглицерин Таблетки Снижают Давление
Изофра При Аденоидах Форум
Ингавирин 900
Фосфат Кальция И Вода
Хондролон Уколы Для Чего Назначают
Глюкозамин Хондроитин Мсм В Капсулах 570мг
2 Изониазид
Левомицетин Температура
Аналоги Омеза В Инъекциях
Превенар Видео
Что Сильнее Панцеф Или Азитромицин
Таблетки Релиф От Геморроя
Ци Клим Инструкция По Применению Цена
Наком Совместимость